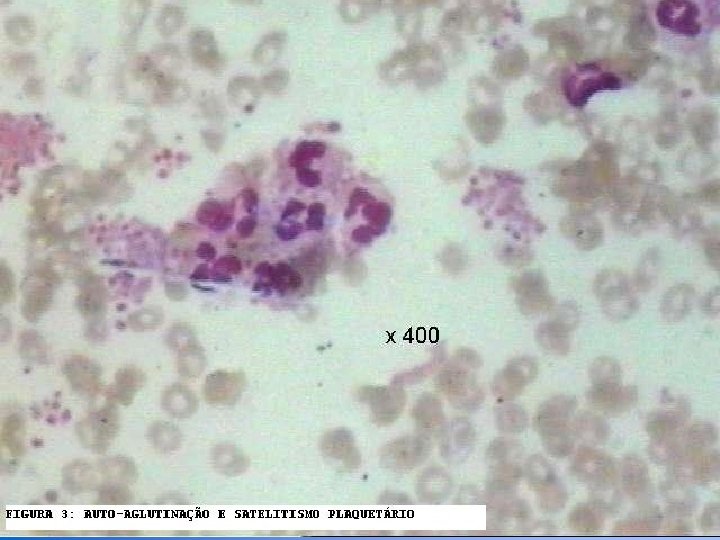

GRANDES TEMAS EM TERAPIA INTENSIVA Como Identificar e

- Slides: 119
GRANDES TEMAS EM TERAPIA INTENSIVA “Como Identificar e Abordar Disfunção plaquetária em Terapia Intensiva ? " Dr. João Carlos de Campos Guerra Departamento de Patologia Clínica-HIAE Centro de Hematologia de São Paulo-CHSP
Conflito de Interesses “NADA A DECLARAR”
SISTEMAS ENVOLVIDOS NA HEMOSTASIA n Hemodinâmico n Vascular n Plaquetário n Coagulação n Fibrinolítico n Inibidores
SISTEMAS ENVOLVIDOS NA HEMOSTASIA Hemodinâmico Hemorragia Fibrinólise Fator Vascular Plaquetário Equilíbrio (Hemostasia) Coagulação Trombose Inibidores Anticoagulantes
Plaqueta n Célula discóide anuclear (3 -5 microns) n Fragmentos do citoplasma de megacariócitos da medula óssea. n Maturação 4 -5 dias, meia vida 9 -10 dias n Membrana bilaminar que contem várias invaginações com um sistema canalicular aberto: – Ligado intracelularmente a um sistema tubular denso, formando uma rede de interconexão através da célula (complexo membrânico) – Facilita a secreção dos grânulos
Célula não nucleada com meia-vida de 7 a 10 dias. Pode reduzir a meia-vida para 3 a 4 dias indicando aumento de consumo, aumento do turnover plaquetário. (geneticamente? patológicamente? ) A estabilidade é conseguida por dois sistemas de canais inter-conectados no interior da plaqueta: a fina rede de ligação do canal –sistema tubular denso (amarelo) e os tubos tipo saco (azul) o qual também promove a conexão com o exterior. Um espiral de microtubulos mantém a forma discóide da plaqueta. A membrana plaquetária estica como um guarda chuva em espiral e circula na corrente sanguínea. A plaqueta é altamente especializada e diferenciada. Além dos dois sistemas de canais apresenta outras organelas (mitocondrias, lisossomos, grânulos de estocagem de glicogênio, etc…).
Organelas da Plaqueta n Mitocondria, Aparelho de Golgi, ribossomos, peroxisomos, lisossomos n Dois tipos de Grânulos de armazenamento: – Grânulos Alpha: Fator 4 Plaquetário , PDGF, fibrinogênio, fibronectina, inibidor I do ativador de plasminogênio (PAI I), Fatores V, VIII, e Fv. W – Corpos Densos: histamina, epinefrina, serotonina, ADP, cálcio
membrana microtubulos Sistema tubular denso Sistema canalicular conectado a superfície Mitocondria Grânulos de glicogênio Grânulos Densos Grânulos α
Citoesqueleto plaquetário n Composto de filamentos de actina cruzados ligados a superfície interna da dupla membrana lipídica n Regula a forma da plaqueta em repouso n Interage com os receptores transmembrânicos n Ativação plaquetária através da cascata de fosforilação proteica intracelular leva a sua contração e liberação do conteúdo das organelas plaquetárias
PLAQUETA Sistema canicular aberto Sistema Tubular Denso Grânulo α Microtubulos Grânulo Denso Filamentos Actínicos Estoque de glicogênio Miosina Mitocondria Degranulação – liberação do conteúdo dos grânulos α e densos Mudança de forma (discóide para esférica) e extensão de pseudópodes
Superfície plaquetária n Possui numerosos receptores G-proteicos ou receptores de adesão (integrinas): – heterodímeros transmembrânicos compostos de subunidades alpha e beta, responsáveis pela adesão e sinais de transdução – São glicoproteinas designadas de I até IX (de forma decrescente conforme tamanho molecular); e de a e b conforme tipo de bandas obtidas por eletroforese
Glicoproteinas receptoras n GP Ib-V-IX: complexo de quatro produtos genicos, serve como um receptor para Fv. W; adesão - (Bernard-Soulier) n GP IIb-IIIa: mais abundante, reconhece os quatro receptores de adesão: fibrinogênio, fibronectina, vitronectina, e Fv. W; agregação - (Glanzmann) n Outros: – GP Ia, IIa; GP VI: receptores do colágeno
Hemostasia Primária n Extremamente dinâmica, interação contínua entre vaso, plaqueta, e componentes do plasma n Adesão, Ativação (Secreção), Agregação
Adesão n Rompimento vascular expõe os componentes prócoagulantes do sub-endotélio (matrix extracelular, colágeno, proteoglicanos, e fibronectina); n O Fv. W atua como uma ponte de adesão entre o complexo GP Ib-V-IX da plaqueta e o colágeno exposto; n As plaquetas aderem-se a fibronectina das microfibrilas subendoteliais; n A associação Fv. W-GPIb é a ligação mais forte para superar a força do fluxo sanguíneo.
Subendotélio
Secreção - Ativação n Mudança da forma de discóide para esférica com extensão de pseudópodes promovida pela contração do citoesqueleto n Conteúdo dos Grânulos plaquetários são liberados através do sistema canalicular n A contração do cito-esqueleto ocorre pelo aumento do Ca iônico intraplaquetário modulado pela redução do AMPc e aumento de ADP proveniente da via das prostaglandinas (TXA 2) n Também são expostos fosfolipídios na superfície da membrana plaquetária, que são receptores dos fatores da coagulação vitamina K dependentes (Fator II, IX, X)
Via das Prostaglandinas Ciclooxigenase Prostaglandinas (AAS) Tromboxane Sintetase (Clopidogrel) - ADP Prostaciclina Sintetase ↓ Ca++ ↑ Prostaciclina (PGI 2): poderoso antiagregante plaquetário e vasodilatador Tromboxane A 2: poderoso agregante plaquetário e vasoconstrictor Drogas Antiagregantes interferem nesses mecanismos
Agregação n A contração da plaqueta provocada pela reação de liberação propicia: – Mudança conformacional dos receptores IIb. IIIa, permitindo a ligação do fibrinogênio – Agregação plaquetária via fibrinogênio – Reação auto-catalítica ativando outras plaquetas – Formação do plug primário hemostático
Sistema de coagulação n Fase de iniciação n Fase de propagação n Fase de formação da fibrina
V Va Fase de Iniciação X VIII/ Fv. W II VIIIa Vlla Va Xa TF IIa Célula que expressa FT Vlla TF IX VIIIa plaqueta II X Xa IIa XI Va IXa Plaqueta ativada Fase de propagação Xla
Ontogênese celular - HEMATOPOESE Pluripotent Stem Cell B Stem Cell Myeloid Stem Cell CFU-GEMM BFU-E BFU-Meg CFU-Meg Proerytoblast Megakaryocyte Erythrocyte Platelets CFU-Bas CFU-GM CFU-G CFU-E Pre B Cell Myeloblast Neutrophilic Myelocyte Neutrophil CFU-M CFU-Eo Monoblast Myeloblast Promonocyte Macrophage Eosinophilic Myelocyte Eosinophil T Stem Cell Prothymocyte CFU-Mast Myeloblast B Lymphoblast T Lymphoblast Basophilic Myelocyte Basophil B Cell Mast Cell Plasma Cell T Cell
Trombopoese Enciclopédia Iberoamericana de Hematologia - Vol. III - Ed 1992 - pág. 69
Trombopoese Enciclopédia Iberoamericana de Hematologia - Vol. III - Ed 1992 - pág. 71
The Role of TPO in Thrombopoiesis Modified with permission from Kaushansky K. Thrombopoietin. N Engl J Med. 1998; 339: 746 -754.
TROMBOCITOPENIA Outras Causas Produção Deficiência da MO Eritropoiese Ineficaz Destruição Transfusão Maciça Hiperesplenismo Não Imunológica Aplasia QT Anemia Megaloblástica CIVD PTT RT SHU Infecção Vasculites Toxina CEC Drogas Infiltração Trombocitopenias Hereditárias Drogas Alo Imune Auto Imune PTI LES P Neonatal LP PPT HIV Fig. Causas da trombocitopenia: MO= medula óssea, QT= quimioterapia, RT= radioterapia, CIVD= coagulação intravascular dissemidada, PTT= púrpura trombocitopênica trombótica, SHU= síndrome hemolítico-urêmica, P Neonatal= púrpura neonatal, PTT= púrpura pós transfusional, PTI= púrpura trombocitopênica imunológica, LES= lúpus eritematoso sistêmico, LP= doenças linfoproliferativas, HIV= vírus da imunodefifiência adquirida, HCV= hepatite por vírus C. HCV
Diagnóstico reais e artefatos em Plaquetopenia Em 45. 000 amostras analisadas, a prevalência de PTCP foi de 46 casos (0, 1%). A avaliação microscópica do “esfregaço a fresco” (sem anticoagulante) é útil para identificar a PTCP. Batels PC, et al: Screening for EDTA-dependnet deviations in platelet counts and abnormalities in platele distribution histogram in pseudothrombocytopenia. Scand J Clin Lab Invest 1997 Nov, 57(7): 629 -36.
Diagnóstico reais e artefatos em Plaquetopenia A pseudotrombocitopenia (PTCP) é um fenômeno de falsa baixa contagem de plaquetas (falsa plaquetopenia), ocasionado pela aglutinação “in vitro” das plaquetas na presença de auto-anticorpos plaquetários e anticoagulantes, sendo mais comum o EDTA. A falha no reconhecimento desta alteração pode resultar em diagnósticos errôneos e tratamentos inapropriados. - Lombarts AJ, et al: Accurate platelet counting in an insidious case of pseudothrombocytopenia. Clin Chem Lab Med 1999 Nov-Dec, 37(11 -12): 1063 -6. - Ahn HL, et al: EDTA-dependent pseudothrombocytopenia confirmed by supplementation of kanamycin; a case report. Korean J Intern Med 2002 Mar, 17(1): 65 -8. - Schrezenmeier H, et al: Anticoagulant-induced pseudothrombocytopenia and pseudoleucocytosis. Thromb Haemost 1995 Mar; 73(3): 506 -13.
Trombocitopenia Imune Diagnóstico de exclusão Ø Hemograma normal exceto isolada plaquetopenia Ø Plaquetas gigantes no esfregaço, sem outras citopenias Ø Exame físico normal exceto sinais de sangramento Ø PTI secundária: ü Dç. Auto-imune Dç. Linfoproliferativa Infecção ü ü
Trombocitopenia Imune secundária Ø Auto-imune: Ø Dçs. Linfoproliferativas: ü Lupus (LES) ü ü LLC LÑH Macroglobulinemia de Waldenstron Ø Infecções: ü HIV HCV H. Pylori Dengue ü ü Sindrome do anticorco antifosfolípides (SAFI) ü Dç. Tireoidiana Imune (Graves) ü Sindrome de Evans ü ü ü
A prevalência da hepatite C (HCV) em pacientes adultos com trombocitopenia imune crônica (PTI). Hematology 2008 ASH Education Program Book
Os potenciais mecanismos de trombocitopenia induzida pelo Helicobacter pylori. Cazzola et al Hematology 2008 ASH Education Program Book
Proporção de Helicobacter pylori (HP), HP-positivos e negativos de pacientes adultos com PTI alcançar uma resposta na contagem de plaquetas. Does Helicobacter pylori Eradication therapy Result in a Platelet count Improvement in Adults with Immune Thrombocytopenic Purpura Regardless of H pylori Infection ? ASH Evidence-based review 2008 Hematology 2008 ASH Education Program Book
Aumento da Destruição - Consumo n Imunológicas Auto-Imune • Rifampicina drogas • Sais de ouro • Quinino, quinidina • Sulfas • Valproato • Heparina
Aumento da Destruição - Consumo n Induzida por Droga: Heparina (TIH) TIH - Ι : ü 5 a 10% (até 30%) dos pacientes ü 7 dias após início do tratamento ü Supressão não imunológica, transitória e moderada, da produção e do número das plaquetas ü reversão espontânea (mesmo mantendo a terapêutica com heparina) ü sangramento é raro Efeito pró-agregação plaquetária ↑ sequestro esplênico Trombocitopenia Blood, 2003; 2955 -2959 British Journal of Haematology, 2006, 133: 259 -269.
Aumento da Destruição - Consumo n Induzida por Droga: Heparina (TIH) TIH - ΙΙ : Trombocitopenia Imunológica induzida por heparina ü Síndrome Imuno-hematológica (Síndrome do “coágulo branco”) ü Grave trombocitopenia: ü 1 – 4 % dos pacientes em uso de HNF ü 0, 5% com HBPM ü A contagem de plaquetas: redução > 50% pré- heparina ( < 100. 000 / mm 3) ü 50 - 60%: complicação trombótica (Trombose venosa > arterial) ü Mortalidade > 25% 5 a 15 dias após primeira exposição a heparina Blood, 2003; 2955 -2959 British Journal of Haematology, 2006, 133: 259 -269.
Aumento do Consumo Induzida por Droga: Heparina (TIH - II) Formação de AC anti complexo H-PF 4 Ativação plaquetária estimulação geração de trombina TROMBOSE Blood, 2003; 2955 -2959 British Journal of Haematology, 2006, 133: 259 -269.
Diagnóstico Laboratorial - TIH Testes Imunológicos – Detectam anticorpos circulantes (Ig. G, Ig. A e Ig. M), anti complexo Heparina - PF 4 Ø ELISA • • Método HPIA ( Asserachrom – Diagnostica Stago ) GTI-PF 4 ( Quest Biomedical) Ø Método Imunológico de partícula em Gel § Alta sensibilidade > 97% § Especificidade limitada 74 – 86%, também detectam Ac. Anti PF 4 –heparina em pacientes sem TIH § Valor preditivo positivo do teste pode ser baixo (range 10 – 90% , dependendo da população) § Valor preditivo negativo é alto (maior que 95%) § A especificidade do teste sorológico para doença clínica pode ser aumentada se somente Acs. Ig. G são mensurados (testes específicos para Ig. G não são comercialmente disponíveis) ( Dia. Med ID – Pa. GIA ) N Engl J Med. 2006 Aug, 355(8): 809 -17
Diagnóstico Laboratorial - TIH Ø Teste Funcional – avalia ativação plaquetária e detecta Acs. Heparina dependente, capazes de ligação e ativação dos receptores Fc nas plaquetas § Sensibilidade > 90% (dependendo da experiência do Labo) § Especificidade 77 – 100% (dependendo do contexto clínico de exposição a heparina) § Teste de liberação de Serotonina marcada com C (14) de plaquetas ativadas Sensibilidade: 88 – 100 % e Especificidade: 89 – 100 % ( teste pouco disponível) § Valor preditivo positivo alto (89 - 100%), § Valor preditivo negativo ( 81%) N Engl J Med. 2006 Aug, 355(8): 809 -17
Heparin – Induced Thrombocytopenia N Engl J Med. 2006 Aug, 355(8): 809 -17
The management of heparin - induced thrombocytopenia British Journal of Haematology, 2006, 133: 259 -269.
Heparin – Induced Thrombocytopenia FLUXOGRAMA – TIH Trombocitopenia em pacientes recebendo HNF ou HBPM Alta ou Intermediaria suspeita clínica de TIH Baixa suspeita clínica de TIH Interromper terapia com HNF ou HBPM, e iniciar tratamento anticoagulante alternativo Terapia com HNF ou HBPM pode ser continuada Resultado do teste imunológico – Considerar diagnóstico alternativo ELISA Positivo com alta suspeita de TIH Positivo com intermediária suspeita de TIH Negativo com alta suspeita de TIH Negativo com intermediária suspeita de TIH confirmada Resultado do teste funcional Considerar diagnóstico alternativo; TIH Indeterminada Considerar diagnóstico alternativo, pode reiniciar a heparina Positivo Negativo TIH provável TIH indeterminada N Engl J Med. 2006 Aug, 355(8): 809 -17
ANVISA - Hospitais da Rede Sentinela Projeto : Avaliação da Incidência de Trombocitopenia Induzida por Heparina Ø Ø • • • • • Estudo Multicêntrico – Dr. Cyrillo Cavalheiro Filho (Coordenador) Samantha C. Oliveira (Gerente Pesquisa) Instituições da Rede Sentinela: Instituto do Coração (In. Cor - HCFMUSP) Instituto Central (HC FMUSP) Hospital das Clínicas da Faculdade de Medicina de Botucatu (UNESP) Centro de Hematologia e Hemoterapia da Universidade de Campinas (UNICAMP) Hospital Israelita Albert Einstein Hospital Sírio Libanês Equipe: Prof. Dr. Francisco Humberto de Abreu Maffei Prof. Dr. Dalton de Alencar Fischer Chamone Dr. Roberto Abi Rached Dr. Élbio Antônio D’Amico Dr. Sérgio Paulo Bydlowski Dra. Paula Vilhaça Dr. Paulo Arbex Dra. Viviane Capellupe Dra. Joyce Maria Annichino Bizzacci Dra. Marjorie Paris Colombini Dr. João Carlos de Campos Guerra Dr. Luiz Francisco Cardoso
Anticorpo anti-plaquetas Método por imunofluorescência indireta Método Direto por Citometria de Fluxo
Anticorpo anti-plaquetas Método por imunofluorescência indireta Método Direto por Citometria de Fluxo
Anticorpo anti-plaquetas Método por imunofluorescência indireta Método Direto por Citometria de Fluxo
Distribuição das Patologias encontradas nos Pacientes com Plaquetopenia Fonte: CHSP (Jan/1997 à Mar/2004) J. C. Guerra, R. H. Kanayama, R. Kuabara, I. Y. Takihi, M. R. Yoshida, R. J. Lázaro, , C. A, Mendes, S. T. Nosawa, N. S. Bacal, E. Ferreia, J. Pasternak, M. W. Faulhaber, L. M. Rosenfeld, C. C. C. Guerra - Hospital Albert Einstein / Centro de Hematologia de São Paulo, Brazil – Low platelet counts: diagnosis using flow cytometry and platelet antibody – Clinical Chemistry Vol. 49, 2003
Fonte: CHSP (Jan/1997 à Mar/2004)
Fonte: CHSP (Jan/1997 à Mar/2004) Guerra et al – Clinical Chemistry Vol. 49, 2003
Fonte: CHSP (Jan/1997 à Mar/2004) Guerra et al – Clinical Chemistry Vol. 49, 2003
Guerra et al – Clinical Chemistry Vol. 49, 2003
Guerra et al – Clinical Chemistry Vol. 49, 2003
Detalhamento das Outras Causas Fonte: CHSP (Jan/1997 à Mar/2004) Guerra et al – Clinical Chemistry Vol. 49, 2003
Pesquisa de Anticorpo Anti-plaquetas (Método Direto) Total de casos 115 pacientes com plaquetopenia. Amostra: 10 ml de sangue em EDTA. Equipamento: Citômetro de Fluxo – EPICS XL-MCL da Beckman Coulter. Material: - Anti-Human Ig. G FITC conjugate SIGMA (F-1641); - CD 41 ou CD 61 PE Immunotech (PN – IM 1416); - Tampão PBS-EDTA. Método: As Plaquetas separadas do sangue total coletada em EDTA, são lavadas e marcadas com CD 41 PE e Ig. G FITC e analisadas no Citômetro de Fluxo. João Carlos C. Guerra, MD, Ruth H Kanayama, Ph. D, Sonia S. Nozawa, Ph. D, Márcia R. Ioshida, Ph. D, Irina Y Takiri, Ph. D, Robson J. Lazaro, Ph. D, Nelson Hamerschlak, MD, Luiz Gastão M. Rosenfeld, MD, Celso Carlos C. Guerra MD and Nydia S. Bacal, MD. Low Platelet Counts: Diagnosis Using Flow Cytometry and Anti Platelet Antibody – Blood (ASH Annual Meeting Abstracts) 2006 108: abstract 3966.
Controle Negativo Plaquetas – 375. 000/mm³ 0. 114 1. 47
CSM CSM/20 anos (Masc. ) Plaquetas – 65. 000/mm³ 2. 58 5. 95
AVS AVS/31 anos (Fem. ) Plaquetas – 16. 000/mm³
Distribuição por Resultado Obtido Anticorpo anti-plaquetas Guerra et al. Low Platelet Counts: Diagnosis Using Flow Cytometry and Anti Platelet Antibody – Blood (ASH Annual Meeting Abstracts) 2006 108: abstract 3966.
Distribuição percentual por Diagnóstico e Resultado Anticorpo anti-plaquetas Guerra et al. Low Platelet Counts: Diagnosis Using Flow Cytometry and Anti Platelet Antibody – Blood (ASH Annual Meeting Abstracts) 2006 108: abstract 3966.
Exame Alterado (Fluxograma) PLAQUETOPENIA REPETIÇÃO CITRATO / EDTA NORMAL DIMINUIDA C MARA FONIO T. T. P. A. PROLONGADO REPETIR APÓS 24 h a 4 ºC EDTA PESQ ANTICOAG CIRC O’ 30’ 60’ NORMAL P. T. I. HIV BERNARD SOULIER Contagem em Câmara DIMINUÍDA Hepatite C ANTI LÚPICO ARTEFACTO Fonte: CHSP HEMOGRAMA c/ BICITOPENIA ELETROFORESE DE PROTEÍNA (CIRROSE / HIPERESPLENISMO)
Conclusão - Geral ü A plaquetopenia é uma achado laboratorial freqüente. ü A PTI é a causa mais comum de plaquetopenia, com maior frequência no sexo Feminino , em crianças entre 1 a 10 anos e adultos jovens entre 15 a 40 anos, conforme dados da literatura. ü Neste trabalho, a faixa de normalidade foi responsável por 15, 7% dos casos (segunda maior causa); o que nos faz questionar os valores de normalidade para contagem de plaquetas utilizados na maioria dos laboratórios.
Conclusão - Geral üA análise microscópica anticoagulante) é do “esfregaço importante pseudotrombocitopenia, na à fresco” identificação macroplaquetas e (sem de alterações morfológicas das linhagens hematopoiéticas. ü O anticorpo anti-plaquetas é um exame útil, quando positivo, para confirmar PTI e importante, quando negativo, para descartar diagnósticos errôneos de plaquetopenias (faixa de normalidade).
Patogênese da PTI Destruição das Plaquetas 1, 2 Autoanticorpos (imunoglobulinas) revestem a superfície das plaquetas Os receptores Fc dos macrófagos ligam-se a anticorpos na superfície das plaquetas As plaquetas são prematuramente destruídas sendo fagocitadas no baço Produção inadequada das Plaquetas 1 -4 Autoanticorpos se ligam a megacariócitos na medula óssea. Os megacariócitos são destruído ou apresentam maturação prejudicada O “turnover” das plaquetas pode estar diminuído, mesmo com níveis de TPO normais References: 1. Chang M, et al. Blood. 2003; 102: 887 -895. 2. Cines DB, et al. Annu Rev Med. 2005; 56: 425 -442. 3. von dem Borne, et al. Blood Rev. 2002; 16: 57 -59. 4. Mc. Millan R, et al. Blood. 2004; 103: 1364 -1369.
MO – PTI X 10
MO – PTI X 10
Achados Clínicos e Evolução da PTI Crianças 1 -5 Adultos 1 -5 Geralmente aguda, transitória (crônica ~10 – 20%) Crônica na maioria dos pacientes Frequentemente após infecção viral ou imunização Não possue relação direta com outras patologias Remissão espontânea 80%– 90% em 2– 8 semanas Remissão espontânea <10% Refratário em 15 – 30% Refratário em 30 – 50% Risco muito baixo de mortalidade ou sangramento severo Mortalidade 8 -16% (refratário); 5% de hemorragia fatal (aguda) References: 1. Stasi R, et al. Mayo Clin Proc. 2004; 79: 504 -522. 2. Cines DB, et al. Annu Rev Med. 2005; 56: 425 -442. 3. George JN, et al. Blood. 1996; 88: 3 -40. 4. Kumar M, et al. Am J Hematol. 2005; 78: 181 -187. 5. Cines DB, et al. Blood. 2005; 106: 2244 -2251.
NÚMERO DE PLAQUETAS TROMBOCITOPENIA E RISCO HEMORRÁGICO 1, 2 5% 20– 50, 000/mm 3 10% 10– 20, 000/mm 3 21% <10, 000/mm 3 0 5 10 15 20 25 RISCO DE HEMORRAGIA References: 1. Elting LS, et al. J Clin Oncol. 2001; 19: 1137 -1146. 2. Weaver CH. http: //patient. cancerconsultants. com/supportive_treatment. aspx? id=995. 2005.
Sinais e sintomas de trombocitopenia Purpura (manchas roxas)— equimoses nas pernas Petequias Escala atual: 1 cm 2 cm 3 cm
Sinais e sintomas de trombocitopenia Sangramento anormal e hemorragia Sangramento anormal de mucosa RNM - hemorragia em SNC pac. com trombocitopenia severa
PTI – TRATAMENTO QUAL PACIENTE DEVE SER TRATADO ?
PTI – TRATAMENTO ADULTO Ø Consenso: ü Observação em pacientes sem sangramento e cont. de plaq. > 30. 000/mm 3 Ø Drogas de 1 a linha: ü Corticosteróides Imunoglobulina Anti-D Ig Ø Tto. de 2 a linha: ü ü ü Esplenectomia Ø Pacientes refratários: ü Rituximab Ø Outras opções terapêutica: ü Vincristina, ciclosporina, azatioprina, danazol Ø Terapias experimentais: ü Receptores agonistas de trombopoetina
PTI – TRATAMENTO ADULTO n Corticoesteróides: Prednisona (1 mg/kg/dia): 60 -85% resposta, < 20% se mantem em 1 ano 5 -7. Dexametasona 40 mg VO – 4 dias, < 50% se mantem em 6 meses 2. n Ig. IV 400 mg/kg/dia x 5 (1 g/kg x 2): > 75% resposta (mas transitório, <10% se mantem) 5 -7. Pacientes com pobre resposta a Ig. IV podem ter alguma doença mediada por célula T 1. n Anti-Rh. D (50 - 75 mcg/kg): Provavelmente tem resposta similar ao IVIG, Hemólise imune, Custo reduzido versus Ig. IV 5 -7. 1. Olsson et al. Nat Med 2003. 2. Cheng et al. N Engl J Med 2003; 349: 831. 3. Godeau et al. , Blood 2008; 112; 999. 4. Zaja F et al. Haematologica 2008; 93: 930. 5. Stasi R, et al. Mayo Clin Proc. 2004; 79: 504 -522. 6. Cines DB, et al. Annu Rev Med. 2005; 56: 425 -442. 7. Cines DB, et al. Blood. 2005; 106: 2244 -2251.
PTI – TRATAMENTO ADULTO n Esplenectomia Laparoscopica: Normalização inicial das plaquetas em 75 – 85% dos casos, porém 25 a 50% de recaída em 5 -10 anos 5 -7. n Rituximab: dose convencional 40% dos pacientes tiveram uma boa resposta em 1 ano, com apenas 30% exibindo uma resposta completa (plaquetas> 150 x 109 / L)3. Com dose reduzida (piloto 28 pacts), 100 mg por semana 4 x , 75% dos pacientes obtiveram uma resposta parcial ou completa , sendo que 35% apresentaram resposta completa 4. n Danazol, vincristina, azathioprina, ciclofosfamida, ciclosporina, MMF, etc 5 -7. 1. Olsson et al. Nat Med 2003. 2. Cheng et al. N Engl J Med 2003; 349: 831. 3. Godeau et al. , Blood 2008; 112; 999. 4. Zaja F et al. Haematologica 2008; 93: 930. 5. Stasi R, et al. Mayo Clin Proc. 2004; 79: 504 -522. 6. Cines DB, et al. Annu Rev Med. 2005; 56: 425 -442. 7. Cines DB, et al. Blood. 2005; 106: 2244 -2251.
O Papel da TPO na Trombopoiese Modified with permission from Kaushansky K. Thrombopoietin. N Engl J Med. 1998; 339: 746 -754.
O que é Trombopoetina ? Uma potente citocina endógena 1, 2 O principal regulador fisiológico da produção de plaquetas 1, 2 Influencia a proliferação e diferenciação dos megacariócitos provenientes das células progenitoras da medula óssea 2 -4 Produzida pelo fígado, Rins e Medula Óssea Seus níveis são regulados pelo receptor c-mpl 3 Receptor Trombopoetina (TPO-R) Localizado na superf[icie da stem cells, celulas progenitoras e megacariócitos References: 1. Vadhan-Raj S, et al. J Clin Oncol. 2003; 21: 3158 -3167. 2. Kuter DJ, Begley CG. Blood. 2002; 100: 3457 -3469. 3. Wolber E-M, Jelkmann W. News Physiol Sci. 2002; 17: 6 -10. 4. Kaushansky K. N Engl J Med. 1998; 339: 746 -754.
O nível de TPO está reduzida na PTI ? Kuwana 2005
Novos Agentes Trombopoiéticos - PTI AMG 531 (Romiplostim) - 10 µg/Kg/dose IV/SC uma vez por semana Aprovado pelo FDA para PTI, estudos para plaquetopenia em SMD e pós QT (fibrose de medula óssea) ELTROMBOPAG – 50 mg VO diário Aprovado pelo FDA para PTI e estudos para plaquetopenia em HCV. Em aprovação na ANVISA AKR-501 – 100 mg VO diário SB-559448 ASH - 2008
ANTIAGREGANTES PLAQUETÁRIOS Antagonistas do Receptor da glicoproteína IIb / IIIa Inibidores do Tromboxane A 2 n n AAS AIÑH Inibidores de agregação plaquetária mediado pelo ADP n TICLOPIDINA ü Ticlid n CLOPIDOGREL ü Plavix, Iscover n ABCIXIMABE ü Reopro n TIROFIBAN ü Aggrastat n EPTIFIBATIDE ü Integrelin
platelet activation mechanisms Arachidonic acid aspirin LMWH adhesion thrombin epinephrine ADP clopidogrel heparin GP IIb/IIIa activation Abciximab PLATELET AGREGATION Tx. A 2
VIAS DE ATIVAÇÃO PLAQUETÁRIA ADP Trombina TXA 2 Plaquetas Local de União do Fibrinogênio Agregação Plaquetária Fibrinogênio
Clopidogrel na via de ativação plaquetária ADP Clopidogrel l e r g o d i p o l C Plaqueta ADP Local de união do fibrinogênio Fibrinogênio União do fibrinogênio reduzida
ESTUDO DA FUNÇÃO CAPILAR E PLAQUETÁRIA n Prova do Laço n TS de IVY n Agregação Plaquetária n PFA-100
TS- Tempo de Sangramento
Tempo de sangramento - Ivy Função Vascular e Plaquetária Pressão: 40 mm. Hg Local: face anterior do antebraço Lanceta 1 cm / 1 mm de profundidade Papel de filtro a cada 30 seg. , evitando tocar as bordas do corte Duas incisões: divergência acima de 1 min devemos investigar a causa Valores normais: 7 a 9 minutos
Estudo da Agregação Plaquetária PRP é preparado em sangue total citratado por leve centrifugação (cerca de 5000 rpm) Agonistas ou agentes Agregantes Aumento da transmi tância da luz Registro cinético pelo Agregômetro
Estudo da Agregação Plaquetária Agentes agregantes n Concentrações diferentes de cada agente levam à formas diferentes de curvas n ADP, ADN e Colágeno permitem a obtenção de curvas com duas ondas. n Primeira onda: efeito direto do agente agregante n Segunda onda: representa a reação de liberação plaquetária n Ácido aracdônico n Ristocetina (antibiótico): teste de aglutinação plaquetária dependente do Fv. W, pode ser realizada com plaquetas fixadas com formol n Defeito na agregação induzida com Ristocetina é característico de Bernard-Soulier Aglutinação das plaquetas, não depende da atividade de liberação
1450 agregações plaquetárias realizadas Trabalho apresentado na SBPC - 2006
AGREGAÇÃO PLAQUETÁRIA
AGREGAÇÃO PLAQUETÁRIA
AGREGAÇÃO PLAQUETÁRIA
Problemas no estudo da agregação plaquetária n Numerosas variáveis afetam a agregação: n Anticoagulante: concentração e volume (citrato de sódio) n Plaquetometria ajustada no PRP – 150. 000 a 250. 000/mm 3 n Distribuição do tamanho plaquetário n Variação circadiana (? ) n Relação com alimentação e atividade física Atividade física diminui a concentração do AMPc – plaquetas “mais sensíveis ao ADP”, pode ser visto na hiperagregação dos atletas ü Ht alterado - corrigir o anticoagulante na coleta ü Tempo não pode ultrapassar 4 horas da coleta ü Na agregação com adrenalina aguardar 30 minutos / 60 minutos
PFA - 100 Fluxo com alto “shear stress” (pressão do deslocamento da lâmina de sangue circulante)
Tromboelastograma
TRATAMENTO ANTIAGREGANTE PLAQUETÁRIO n Não existe medicação que reverta a ação destas medicações n Cirurgias: Quando possível suspender medicação de 7 a 14 dias antes do procedimento n Procedimentos invasivos (EDA) não é necessário suspender o AAS / AIÑH n Em casos de intercorrência está indicado transfusão de concentrado de plaquetas
Resistência à Aspirina
Prevalência da Resistência à Aspirina – 325 mg
Prevalência da Resistência à Aspirina
Resistência à Aspirina
Resistência ao Clopidogrel
Clopidogrel: Resistencia: dose -dependente
Clopidogrel: Resistencia: dose -dependente
Clopidogrel: Doses-Efeitos
Resistência à Aspirina e ao Clopidogrel Definições ü Resistência à Aspirina: • Requer 2 dos seguintes itens: • Agregação Plaquetária induzida pelo AA 0. 5 mg/ml ≥ 20% • Agregação Plaquetária induzida por 5 umol/L de ADP ≥ 70% • RPFA-ASA ARU ≥ 550 ü Resistência ao Clopidogrel: • Diferença absoluta entre agregação basal e pós tratamento ≤ 10% em resposta a ambos 5 e 20 umol/L de ADP. • The Dually Resistant Patient. Neal Kleiman, MD, FACC. ACC
IMPACT (immediate microscopic platelet adhesion cone and plate technology) Dia. Med IMPACT-R Based upon cone and platelet viscometer developed by Varon A 130 ul of whole blood (citrated) is placed in a polystyrene plate Shear rate of 1800/s is applied for 2 minutes Platelets adhere and aggregate on the plate surface Washing and staining The plate is placed under a microscope connected to an image analysis system and a computer Successive images of different fields of the plate are taken and the percentage of the well covered by the stained objects and the average size of these objects are quantified
AVALIAÇÃO DA AGREGAÇÃO PLAQUETÁRIA
CONCLUSÕES üResistência à Aspirina e ao Clopidogrel : Ø É multi-fatorial Ø Não há uma definição amplamente aceita do melhor método para identificar os pacientes resistentes Ø Há necessidade de novos estudos que comprovem que os pacientes resistentes realmente apresentam evolução desfavorável no seguimento clínico Ø Baseado nos estudos disponíveis, a conduta mais indicada para estes pacientes seria o aumento da dose da medicação
OBRIGADO DR. JOÃO CARLOS DE CAMPOS GUERRA Departamento de Patologia Clínica-HIAE Centro de Hematologia de São Paulo-CHSP jcguerra@einstein. br